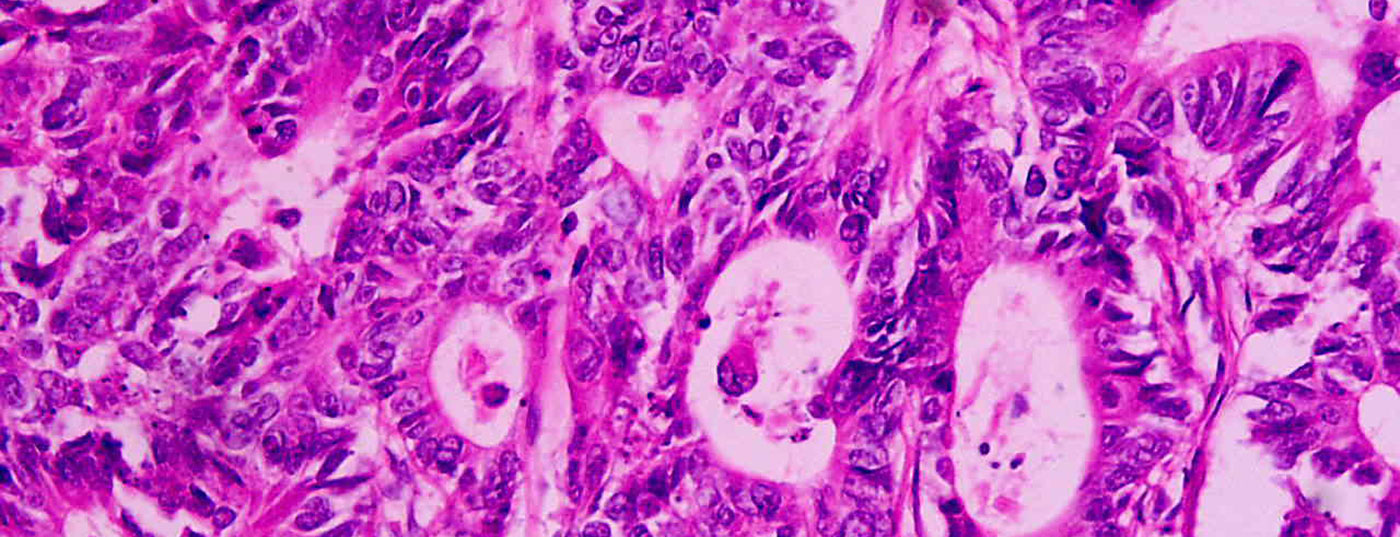
rektumkarzinom_wikipedia

Die Behandlung des kolorektalen Karzinoms hat sich stark verbessert. Patienten profitieren heute auch in fortgeschrittenen Stadien und bei Metastasen von multimodalen Therapieansätzen. Das Management muss interdisziplinär erfolgen.
Die Behandlung des kolorektalen Karzinoms hat sich stark verbessert. Patienten profitieren heute auch in fortgeschrittenen Stadien und bei Metastasen von multimodalen Therapieansätzen. Das Management muss interdisziplinär erfolgen.
Gib dein Suchwort ein und drücke Enter.
